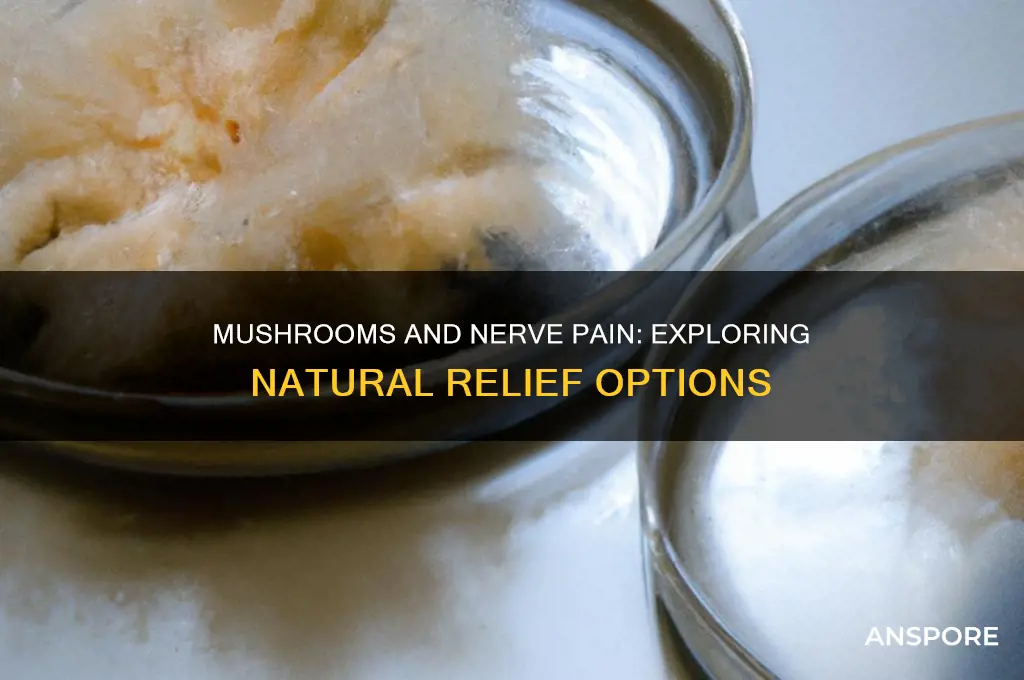
do mushrooms help with nerve pain

Mushrooms have gained attention in recent years for their potential therapeutic benefits, including their role in managing nerve pain. Certain species, such as *Lion’s Mane* and *Reishi*, contain bioactive compounds like beta-glucans, hericenones, and erinacines, which are believed to support nerve regeneration, reduce inflammation, and modulate the nervous system. Research suggests that *Lion’s Mane*, in particular, may stimulate nerve growth factor (NGF), a protein essential for the health and repair of neurons, potentially alleviating symptoms of neuropathic pain. Additionally, the anti-inflammatory and antioxidant properties of medicinal mushrooms may help address underlying causes of nerve pain, such as chronic inflammation or oxidative stress. While preliminary studies and anecdotal evidence are promising, more rigorous clinical research is needed to fully understand their efficacy and mechanisms in treating nerve pain.
| Characteristics | Values |
|---|---|
| Scientific Evidence | Limited; some studies suggest anti-inflammatory and neuroprotective properties in certain mushrooms, but direct evidence for nerve pain relief is inconclusive. |
| Mushroom Types | Lion's Mane, Reishi, Chaga, and Cordyceps are commonly studied for potential nerve pain benefits. |
| Mechanism of Action | May reduce inflammation, modulate nerve growth factor (NGF), and protect neurons, but research is preliminary. |
| Clinical Trials | Few human trials specifically targeting nerve pain; most evidence is anecdotal or from animal studies. |
| Safety | Generally considered safe when consumed in moderate amounts, but individual reactions may vary. |
| Dosage | No standardized dosage; typically consumed as supplements, teas, or extracts. |
| Side Effects | Rare, but may include digestive issues, allergic reactions, or interactions with medications. |
| Expert Opinion | Experts caution against relying solely on mushrooms for nerve pain; they may complement, not replace, conventional treatments. |
| Availability | Widely available as supplements, powders, or fresh/dried mushrooms in health food stores and online. |
| Conclusion | Promising but not yet proven; further research is needed to confirm efficacy for nerve pain relief. |
Explore related products
What You'll Learn

Mushroom compounds and nerve pain relief
Mushroom compounds have gained attention for their potential role in alleviating nerve pain, a condition often challenging to manage with conventional treatments. Among the most studied compounds are beta-glucans, polysaccharides found in the cell walls of mushrooms like Reishi (*Ganoderma lucidum*) and Lion’s Mane (*Hericium erinaceus*). Beta-glucans are known for their immunomodulatory properties, which can indirectly benefit nerve pain by reducing inflammation, a common contributor to neuropathic discomfort. Chronic inflammation can exacerbate nerve damage and pain, and beta-glucans may help by regulating the immune response and minimizing tissue irritation.
Another key compound is hericenone, found in Lion’s Mane mushrooms, which has been shown to stimulate nerve growth factor (NGF) synthesis. NGF is essential for the growth, maintenance, and survival of neurons, making it particularly relevant for neuropathic pain conditions. By promoting nerve regeneration, hericenones may help repair damaged nerves and reduce pain signals. Studies in animal models have demonstrated that Lion’s Mane extracts can improve recovery in nerve injuries, suggesting a direct application for nerve pain relief in humans.
Cordycepin, a compound found in Cordyceps mushrooms, is also noteworthy for its anti-inflammatory and analgesic properties. It works by inhibiting pro-inflammatory pathways, such as NF-κB, which play a significant role in chronic pain conditions. Additionally, cordycepin has been shown to modulate ion channels involved in pain signaling, potentially reducing the hypersensitivity associated with nerve pain. This dual action makes Cordyceps a promising candidate for managing neuropathic pain.
Erinacines, another group of compounds found in Lion’s Mane, further contribute to nerve pain relief by enhancing myelination—the process of forming a protective sheath around nerves. Improved myelination can enhance nerve conduction and reduce the misfiring of pain signals, a common issue in neuropathic pain. Clinical trials have indicated that regular consumption of Lion’s Mane extracts may lead to measurable improvements in neuropathy symptoms, particularly in diabetic patients.
Lastly, the antioxidant properties of mushroom compounds, such as ergothioneine found in shiitake and oyster mushrooms, play a crucial role in nerve pain management. Oxidative stress is a significant factor in nerve damage and chronic pain, and ergothioneine’s ability to neutralize free radicals can protect nerves from further deterioration. Incorporating these mushrooms into the diet or taking standardized extracts may provide a natural, complementary approach to alleviating nerve pain. However, it is essential to consult healthcare professionals before starting any new treatment, especially for those with underlying health conditions.
The Perfect Chilli: Mushrooms, Yes or No?
You may want to see also

Lion’s Mane mushroom for nerve regeneration
While research is still evolving, Lion's Mane mushroom (Hericium erinaceus) has emerged as a promising natural candidate for supporting nerve regeneration and potentially alleviating nerve pain. This fascination stems from its unique bioactive compounds, particularly hericenones and erinacines, which have demonstrated neuroprotective and neuroregenerative properties in various studies.
Nerve damage, often caused by injury, disease, or degeneration, can lead to chronic pain, numbness, and tingling. Conventional treatments often focus on symptom management, but Lion's Mane offers a potentially novel approach by targeting the underlying cause: damaged nerves.
Studies have shown that Lion's Mane extracts can stimulate the production of Nerve Growth Factor (NGF), a protein crucial for the growth, maintenance, and survival of neurons. NGF plays a vital role in repairing damaged nerves and promoting the formation of new nerve cells. In animal models, Lion's Mane supplementation has been shown to accelerate nerve regeneration after injury, leading to improved motor function and reduced pain sensitivity.
A 2013 study published in the journal "Phytotherapy Research" found that Lion's Mane extract significantly improved nerve regeneration and reduced pain in rats with sciatic nerve injury. Another study, published in "Biomedical Research" in 2012, demonstrated that Lion's Mane extract promoted neurite outgrowth in cultured rat dorsal root ganglion neurons, indicating its potential to stimulate nerve cell growth.
While animal studies are promising, human research on Lion's Mane for nerve regeneration is still limited. However, preliminary studies suggest potential benefits. A small pilot study published in the "International Journal of Medicinal Mushrooms" in 2011 reported improvements in neurological symptoms and quality of life in patients with mild cognitive impairment after taking Lion's Mane extract for 16 weeks.
It's important to note that more extensive clinical trials are needed to confirm the efficacy and safety of Lion's Mane for nerve regeneration in humans. However, the existing research provides a compelling rationale for further investigation.
If you're considering using Lion's Mane for nerve pain, it's crucial to consult with your healthcare provider first. They can advise on appropriate dosage, potential interactions with medications, and monitor your progress. Lion's Mane is generally considered safe, but individual reactions can vary.
In conclusion, while research is ongoing, Lion's Mane mushroom shows promising potential as a natural adjunctive therapy for nerve regeneration and pain management. Its ability to stimulate NGF production and promote nerve cell growth makes it a fascinating area of study for those seeking alternative approaches to nerve-related conditions. As research progresses, we can expect to gain a clearer understanding of Lion's Mane's role in supporting nerve health and potentially alleviating nerve pain.
Psilocybin Mushrooms: A Historical Discovery
You may want to see also

Anti-inflammatory effects of mushrooms on nerves
Mushrooms have gained attention for their potential anti-inflammatory properties, which may contribute to alleviating nerve pain. Nerve pain, often associated with conditions like neuropathy, multiple sclerosis, or sciatica, involves inflammation as a key component. Certain mushrooms contain bioactive compounds such as polysaccharides (e.g., beta-glucans), terpenoids, and phenolic compounds, which have been shown to modulate the immune response and reduce inflammation. These compounds can inhibit pro-inflammatory cytokines like TNF-alpha, IL-6, and IL-1beta, which are often elevated in neuropathic pain conditions. By targeting these inflammatory pathways, mushrooms may help mitigate the underlying causes of nerve pain.
One of the most studied mushrooms for its anti-inflammatory effects is *Lion's Mane (Hericium erinaceus)*. It contains hericenones and erinacines, which stimulate nerve growth factor (NGF) synthesis while also reducing inflammation. Studies suggest that Lion's Mane can suppress the activation of microglia and astrocytes, cells in the nervous system that contribute to neuroinflammation. This dual action—promoting nerve regeneration and reducing inflammation—makes Lion's Mane a promising candidate for managing nerve pain. Incorporating Lion's Mane into the diet or as a supplement may provide therapeutic benefits for individuals suffering from neuropathic pain.
Another mushroom with potent anti-inflammatory properties is *Reishi (Ganoderma lucidum)*. Reishi contains triterpenoids, which have been shown to inhibit the production of inflammatory mediators and reduce oxidative stress. Chronic inflammation and oxidative damage often exacerbate nerve pain, and Reishi's ability to combat these processes can offer relief. Additionally, Reishi modulates the immune system, preventing excessive inflammatory responses that may damage nerve tissues. Regular consumption of Reishi, whether in tea, tincture, or supplement form, may help manage the inflammatory aspects of nerve pain.
Chaga (Inonotus obliquus) is another mushroom known for its anti-inflammatory and antioxidant effects. Rich in melanin and betulinic acid, Chaga reduces inflammation by suppressing NF-κB, a protein complex that plays a central role in inflammatory responses. By inhibiting NF-κB activation, Chaga can decrease the production of inflammatory cytokines and enzymes that contribute to nerve pain. Its high antioxidant content also protects nerves from oxidative damage, a common factor in neuropathic pain. Incorporating Chaga into one's routine, such as through teas or extracts, may support nerve health and reduce pain symptoms.
Lastly, *Turkey Tail (Trametes versicolor)* is recognized for its immunomodulatory and anti-inflammatory properties. Its polysaccharide-K (PSK) and polysaccharide-peptide (PSP) compounds have been shown to regulate immune responses, reducing inflammation while enhancing overall immune function. By balancing the immune system, Turkey Tail can help prevent chronic inflammation that contributes to nerve pain. Additionally, its antioxidant properties protect nerves from damage caused by free radicals. Including Turkey Tail in the diet or as a supplement may offer a natural approach to managing inflammation-related nerve pain.
In conclusion, mushrooms like Lion's Mane, Reishi, Chaga, and Turkey Tail exhibit significant anti-inflammatory effects that can help address nerve pain. Their bioactive compounds target inflammatory pathways, reduce oxidative stress, and support nerve health, making them valuable additions to pain management strategies. While more research is needed to fully understand their mechanisms, incorporating these mushrooms into one's diet or supplement regimen may provide a natural and holistic approach to alleviating neuropathic pain. Always consult a healthcare professional before starting any new treatment, especially if you have underlying health conditions.
Portabella Mushrooms: Constipation Cause or Cure?
You may want to see also
Explore related products

Reishi mushroom and neuropathic pain studies
Reishi mushrooms, scientifically known as *Ganoderma lucidum*, have been a staple in traditional medicine for centuries, particularly in East Asia, where they are revered for their potential health benefits. In recent years, scientific interest has grown in their role in managing neuropathic pain, a chronic condition often resistant to conventional treatments. Neuropathic pain arises from damage or dysfunction in the nervous system, leading to symptoms like burning, tingling, or shooting pain. Preliminary studies suggest that Reishi mushrooms may offer therapeutic effects due to their anti-inflammatory, antioxidant, and neuroprotective properties. These properties are attributed to bioactive compounds such as triterpenes, polysaccharides, and peptidoglycans, which are believed to modulate pain pathways and reduce nerve inflammation.
One of the key mechanisms by which Reishi mushrooms may alleviate neuropathic pain is through their ability to suppress neuroinflammation. Chronic inflammation plays a significant role in the development and persistence of neuropathic pain. Research has shown that Reishi extracts can inhibit pro-inflammatory cytokines like TNF-α and IL-6, which are often elevated in neuropathic conditions. A 2018 study published in *Pharmacognosy Magazine* demonstrated that Reishi extracts reduced mechanical allodynia (pain from non-painful stimuli) in rats with induced neuropathy, suggesting a potential analgesic effect. While animal studies are promising, more human trials are needed to confirm these findings and establish optimal dosages.
Another area of interest is Reishi's antioxidant activity, which may protect nerves from oxidative stress, a common factor in neuropathic pain. Oxidative damage to nerve cells can exacerbate pain signals and impair nerve function. Reishi mushrooms contain potent antioxidants, such as ergothioneine and polysaccharides, which scavenge free radicals and reduce oxidative stress. A study in the *Journal of Ethnopharmacology* (2017) highlighted that Reishi supplementation improved nerve conduction and reduced pain behaviors in diabetic neuropathic rats, possibly by mitigating oxidative damage. These findings underscore the mushroom's potential as a complementary therapy for conditions like diabetic neuropathy.
Clinical studies on Reishi and neuropathic pain in humans are still limited but show promise. A small pilot study published in *Integrative Medicine Insights* (2019) reported that patients with neuropathic pain experienced reduced pain intensity and improved quality of life after eight weeks of Reishi supplementation. However, the study's sample size was small, and larger, randomized controlled trials are necessary to validate these results. Researchers emphasize the need for standardized Reishi extracts to ensure consistency in active compounds and therapeutic effects.
In conclusion, Reishi mushrooms hold potential as a natural adjunctive therapy for neuropathic pain, supported by their anti-inflammatory, antioxidant, and neuroprotective properties. While preclinical studies and limited human trials are encouraging, further research is essential to fully understand their efficacy, safety, and mechanisms of action. Individuals considering Reishi for neuropathic pain should consult healthcare professionals, especially when combining it with existing treatments. As the scientific community continues to explore the therapeutic potential of medicinal mushrooms, Reishi remains a compelling candidate for managing this challenging condition.
Mushroom Varieties: A World of Diversity
You may want to see also

Cordyceps mushroom for nerve health support
Cordyceps mushrooms, a genus of fungi that includes over 400 species, have gained significant attention for their potential health benefits, particularly in supporting nerve health and alleviating nerve pain. Among the various types, *Cordyceps sinensis* and *Cordyceps militaris* are the most studied for their therapeutic properties. These mushrooms are rich in bioactive compounds such as cordycepin, polysaccharides, and antioxidants, which contribute to their neuroprotective effects. Research suggests that Cordyceps may help reduce inflammation and oxidative stress, both of which are common contributors to nerve pain and neuropathy. By modulating these pathways, Cordyceps mushrooms can potentially provide relief for individuals suffering from conditions like diabetic neuropathy, sciatica, or nerve damage caused by injury or illness.
One of the key mechanisms by which Cordyceps supports nerve health is through its anti-inflammatory properties. Chronic inflammation can exacerbate nerve pain and damage, but Cordyceps contains compounds that inhibit pro-inflammatory cytokines and enzymes. For instance, cordycepin, a nucleoside derivative found in Cordyceps, has been shown to suppress inflammation by reducing the production of molecules like TNF-α and IL-6. Additionally, the polysaccharides in Cordyceps stimulate the immune system in a balanced way, preventing excessive inflammation while promoting healing. This dual action makes Cordyceps a promising natural remedy for managing nerve pain associated with inflammatory conditions.
Cordyceps mushrooms also exhibit potent antioxidant effects, which are crucial for protecting nerves from oxidative damage. Oxidative stress, caused by an imbalance between free radicals and antioxidants in the body, can lead to nerve degeneration and pain. Cordyceps is rich in antioxidants such as superoxide dismutase (SOD) and glutathione, which neutralize free radicals and reduce oxidative stress. Studies have shown that supplementation with Cordyceps can improve nerve function and reduce pain symptoms in animal models of neuropathy. These findings suggest that Cordyceps may be particularly beneficial for individuals with nerve pain caused by oxidative stress, such as those with diabetes or aging-related nerve issues.
Another important aspect of Cordyceps' role in nerve health support is its ability to enhance energy production at the cellular level. Cordyceps has been traditionally used to combat fatigue and improve stamina, and its energizing effects extend to nerve cells as well. The mushroom increases the production of adenosine triphosphate (ATP), the primary energy currency of cells, by enhancing mitochondrial function. Healthy mitochondria are essential for maintaining the integrity and function of nerve cells, which are highly energy-dependent. By boosting cellular energy, Cordyceps can help nerves recover from damage and function more efficiently, potentially reducing pain and improving overall nerve health.
Incorporating Cordyceps into a nerve health regimen can be done through various forms, including capsules, powders, or extracts. It is important to choose high-quality supplements from reputable sources to ensure potency and purity. While Cordyceps is generally considered safe, individuals with autoimmune disorders or those taking immunosuppressive medications should consult a healthcare provider before starting supplementation. Combining Cordyceps with a balanced diet, regular exercise, and other nerve-supportive practices, such as acupuncture or physical therapy, can maximize its benefits. As research continues to uncover the full potential of Cordyceps mushrooms, they stand out as a natural and holistic option for supporting nerve health and alleviating nerve pain.
Enoki Mushrooms: What Are They?
You may want to see also
Frequently asked questions
Some mushrooms, like Lion's Mane and Reishi, contain compounds that may support nerve health and reduce inflammation, potentially helping with nerve pain. However, scientific evidence is still limited, and more research is needed.
Lion's Mane mushroom is often highlighted for its potential neuroprotective properties, while Reishi and Chaga are known for their anti-inflammatory effects, which may indirectly support nerve pain relief.
Mushrooms like Lion's Mane may stimulate nerve growth factor (NGF), promoting nerve regeneration. Others, like Reishi, contain triterpenes and polysaccharides that reduce inflammation and oxidative stress, which can contribute to nerve pain.
While generally safe, some individuals may experience allergies or digestive issues. It’s important to consult a healthcare provider before using mushrooms medicinally, especially if you’re on medications or have underlying health conditions.

























